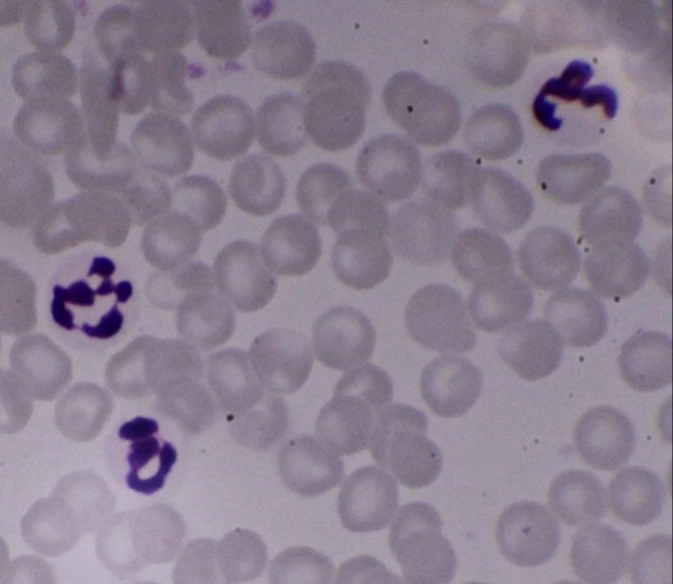

Microscope SLR DSLR Camera Connect Adapter for Canon EOS Nikon Sony Pentax Olympus
11.68
$
24
orders
/
7
reviews
Price history
- for 3 month
- for half a year
- Requires Alitools extension
The Alitools extension is required to keep track of an item and receive notifications when prices drop.
Price drop notification
11.10 $ (-5%)
11.10 $ (-5%)
10.51 $ (-10%)
9.93 $ (-15%)
9.34 $ (-20%)
Out telegram bot will notify you once the price drops to the desirable one
This item is from other sellers
Similar Products
Customer Reviews
A***i
January 7, 2021
very good quality
A***n
October 25, 2020
For the price it is not bad, but it doesn't have precise dimensions so I have to cut it so it fits in ocular hole of my microscope.
Anonymous